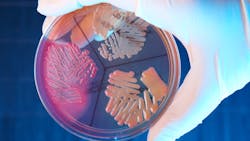
Dreamstime Xxl 12943375 64ad56624876a Dreamstime Xxl 12943375 64ad56624876a

Microbial predators can affect wastewater bacteria with changing seasons
A new study looks into the effects of seasonal fluctuations on microbial communities in wastewater, finding that temperature variations often influence microbial predictor populations, which then change the makeup of the microorganisms in water treatment.
This study was conducted by Nils Heck and PD Dr Kenneth Dumack from the University of Cologne’s Institute of Zoology. The study has been published under the title ‘Microeukaryotic predators shape the wastewater microbiome’ in the journal Water Research.
In wastewater treatment plants, a precisely coordinated interaction of different microorganisms takes place in order to effectively treat wastewater. However, a large part of the microorganisms involved in water treatment is still unknown. In addition to the beneficial bacteria that are responsible for purifying wastewater, many of their predators can also be found in the bioreactors. However, little is known so far about whether and to what extent these predators influence wastewater treatment.
Since the introduction of wastewater treatment plants, it has been known that the seasons influence the bacterial community in wastewater, and thus also the efficiency of water treatment. But why is this so? This question is by no means trivial, as seasonal changes are the result of a variety of factors.
The best-known factors are certainly temperature and light conditions. However, the chemical composition of the wastewater, precipitation amounts and many other factors also vary with the changes throughout the year.
“We found that seasonal variation in ambient temperature cannot explain the variation in the bacterial community,” said Dumack. “This surprised us, so we looked for another factor that could explain the variation in the bacterial community.”
The team found that microbial predators were greatly influenced by temperature changes.
“We found that the community of microbial predators, such as amoebae, ciliates and also rotifers, can explain the composition of the bacterial community to a certain extent,” said Heck, first author of the study. “These predators are in turn dependent on the ambient temperature. Thus, the temperature factor represents an indirect influence on the bacteria through the community of predators.”
The new findings contribute to a better understanding of microbial processes in wastewater treatment.